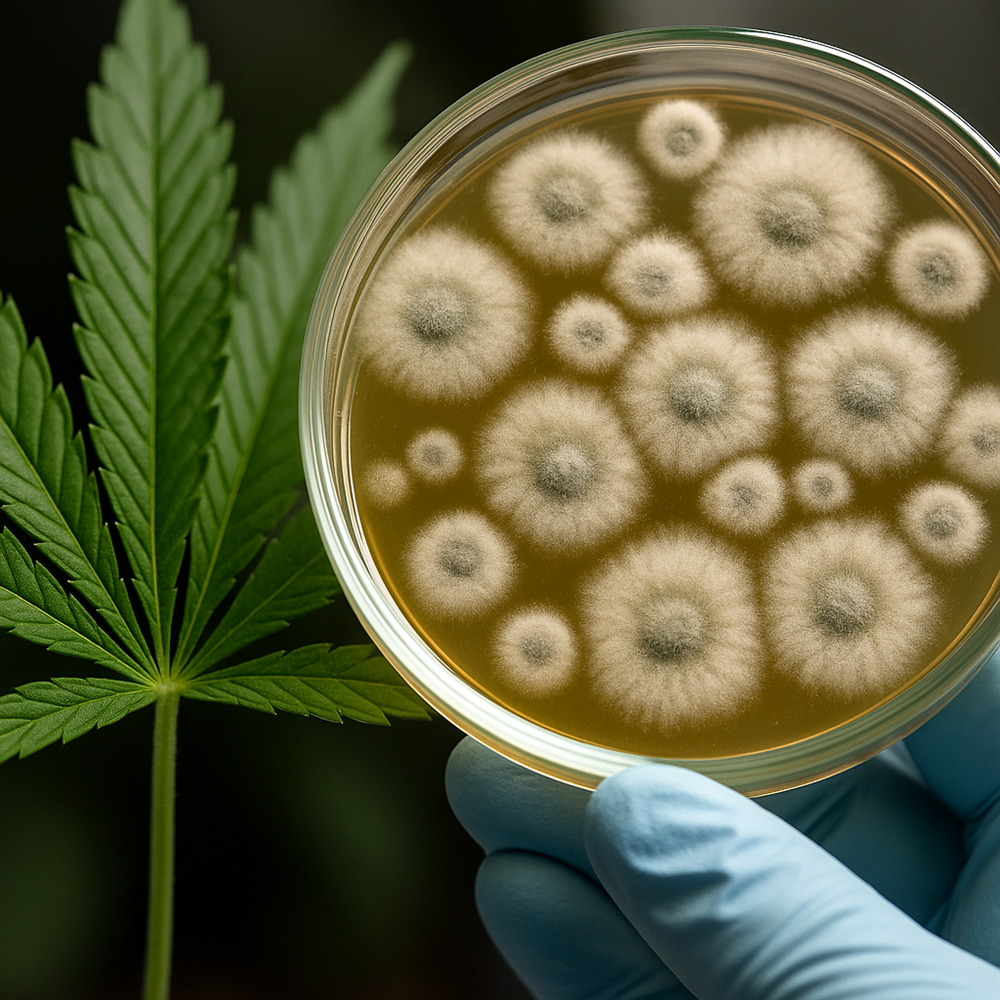

في اكتشاف علمي مذهل، توصل باحثون إلى أن أحد المركبات الموجودة في نبات القنب يمتلك خصائص مضادة للفطريات، ويمكن أن يكون خط الدفاع الجديد ضد نوع قاتل من العدوى الفطرية يهدد حياة الإنسان، خاصة في حالات ضعف المناعة.
الدراسة، التي نُشرت في مجلة علمية مرموقة، ركزت على مركب يسمى "كانابيغيرول (CBG)" – وهو مركب غير نفسي التأثير يوجد بكميات صغيرة في القنب. واكتشف العلماء أن هذا المركب فعال في مواجهة فطر Candida auris، وهو فطر معروف بمقاومته الشديدة للعقاقير وارتفاع معدلات الوفاة بسببه داخل المستشفيات.
لماذا Candida auris خطير؟
-
مقاوم لأغلب مضادات الفطريات التقليدية
-
يسبب التهابات دموية قاتلة
-
ينتشر بسرعة في بيئات المستشفيات
-
تم تصنيفه كتهديد صحي عالمي
كيف يعمل CBG؟
🔬 يمنع نمو الفطر ويمنع تكوّن الأغشية الحيوية التي تساعده على البقاء
🧬 يؤثر على أغشية الخلايا الفطرية دون التأثير على الخلايا البشرية
💊 يمكن استخدامه مستقبلاً لتطوير أدوية موضعية أو جهازية ضد العدوى الفطرية
الدراسة لا تروج لاستخدام القنب العشوائي، لكنها تسلط الضوء على أهمية البحث في المركبات النباتية كمصدر لعلاجات طبية محتملة. ما زال الطريق طويلًا قبل استخدام CBG في المستشفيات، لكن النتائج الأولية واعدة جدًا.